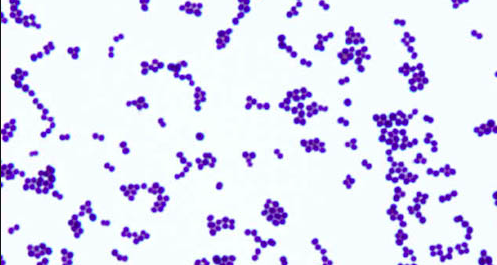

If a woman has a urine dipstick test and tests positive for leukocyte esterase but negative for nitrates, what does this mean?
(honeymoon cystitis)
What is the most common organism causing a catheter acquired UTI?
Staph epidermidis

What is the most common presenting complaint of a male with a UTI?
Dysuria
Why may a patient have ankle oedema and high serum creatinine with SLE?
Oedema: nephrotic syndrome, loss of oncotic pressure in the blood as hypoalbuminemia so loss of fluid to interstitium
Creatinine: immune deposits in the blood causin ischameia and cell death of muscles
What is the definition of an AKI?

How much of the cardiac output does the kidney recieve?
25%
What are the some of the criteria used by NICE for an AKI?

What are the two types of AKI?
- Oliguric or non-oliguric

What is uraemia?
Signs anf symptoms of kidney failure characterised by a raised level of urea in the blood

What are the three different classifications of causes of AKI and some examples of each?
- Prerenal: decreased renal perfusion, is reversible if recognised quickly. 85% of AKIs, e.g sepsis, hypovolaemia
- Renal: usually acute tubular injury (ATI), drugs, rhabdomyolysis, myeloma
- Post renal: obstruction to urine flow in one of three places. 10-15% of AKIs

How can pre-renal AKI become intrinsic AKI?

How can we treat AKI?
- Correctly manage fluid and electrolytes

How does the treatment for intrinsic AKI differ to pre/post renal AKI?
Intrinsic treatment often requires immunosuppressants but the others require supportive treatment
What is the first test that should be done when you suspect an AKI?
Urine dipstick
What is fibromuscular dysplasian?

What is the mortality of AKI?
25% TO 50% depending on co-morbidities

What are the stages of CKD?

What are some of the causes of CKD?

What are some drugs that can cause intrinsic AKI?
What will happen to a patients serum urea in the following scenarios:
- Bleed: raised urea as blood Hb is digested so more urea. If someone has raised urea but not raised creatinine suspect this
- Volume: increase as more ADH so more UT1
- Malnutrition: decrease due to enzymes in the urea cycle
What is the definition of acute tubular injury and what are some risk factors for this?
Damage to kidney tubule cells due to ischaemia or nephrotoxic drugs
Risk factors are anything causing renal failure

What is this patient’s acid base status and why do they have a low bicarbonate level?

What are the causes of elevated anion gap metabolic acidosis?
- High gap: often due to lactic acidosis, ketoacidosis and methanol intake which react with bicarbonate to produce another anion
- Normal gap: low bicarb so chloride increases to compensate
https://www.youtube.com/watch?v=7657dEp51so

What has caused this lady’s AKI and are her serum sodium and potassium what we expect?
